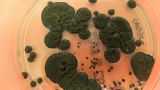

神への讃歌でハイになる?Z世代が熱狂するバジャン・クラビングとは?(インド)
記事の本文にスキップ
この画像を大きなサイズで見るここ数年、インドのZ世代の間に新たなトレンド「バジャン・クラビング」が登場し、都市部の若者たちのナイトライフを変えつつあるという。
彼らが集うのは、EDMとアルコールが支配するダンスフロアではない。伝統的な神々への讃歌「バジャン」とクラブが融合した、魂を揺さぶるセッションなのだ。
若者たちはそこでマントラを詠唱し、スピーカーから流れる神々への讃歌「バジャン」に合わせて踊り、手を叩き、一体感に満ちた「熱狂」に身をゆだねる。
アルコール離れやウェルネス志向が強まる中、若者たちはバジャン・クラビングを「心を整える時間」として、日常に取り入れようとしているようだ。
- 記事をシェア
- コメント
- コメント
を見る
神々への讃歌で「クリーンなハイ」を体験
ニューデリーやムンバイなどインドの大都市では、週末の夜になると、街の喧騒に混じってギターや太鼓の音が、お香の香りといっしょに街路に漏れ出してくることがある。
集まって来るのはZ世代を中心とした若者たち。一見すると、都会にありがちなナイトライフの始まりのようだが、そこには酒もドラッグもない。
暗い照明にスモークが漂い、音響だけはクラブさながら。にもかかわらず、その中心にあるのはヒンドゥー教の神々に捧げる讃歌なのだ。
こうした集まりは「バジャン・クラビング」と呼ばれ、インドの若者たちの新しいトレンドとして広まりつつあるという。
バジャンとは本来、ヒンドゥー教の寺院や家庭の祭壇の前で歌われる伝統的な讃歌のことだ。
信者たちは集団で神への讃歌を唱え、同じフレーズを反復することで意識を内側へと導き、トランス状態の高揚の中で神との一体化を目指す。
バジャン・クラビングとは、言うなればこのバジャンがナイトクラブと出会い、融合したようなものだ。
会場に集まった全員がいっしょにバジャンを歌い、リズムに合わせて踊り、熱狂する。祈りとレイブが同じ場で重なり、参加者は一体感の波に没入していく。
そこにアルコールやドラッグは必要ない。会場で振る舞われるのは、チャイやバターミルクなど素朴な飲み物や軽食が中心である。
自分を失わずに「クリーンなハイ」を体験できることが、若者たちの心をとらえているのかもしれない。
人との繋がりを求める若者たち
経済発展が著しい現在、インドの都市部は急速に西洋化しつつある。特に大都市での生活は多様化し、若者たちの価値観も大きく変わってきた。
男女問わず、一人暮らしやシェアハウスなどで生活をする層も現れはじめ、ストレスや孤独に苦悩する若者たちも増えている。
そんな中で起こった新型コロナウイルスによるロックダウンは、彼らにとっては大きな試練でもあった。
人と会えない時間が続いたことで孤独に苛まれた時、デジタルネイティブなZ世代の若者たちは、インターネットに過度に依存するようになったのだ。
そしてパンデミックが終わり、生身の人と人との繋がりが戻ってきた時、彼らは一種の精神的な「リセット」を余儀なくされることとなった。
この画像を大きなサイズで見る心理学者のプーナム・シャルマ氏は、その時の状況を次のように指摘している。
多くの若者が「現実世界での繋がり」を渇望し、そのための指針として、スピリチュアリティに目を向けるようになったのです
このムーブメントを外から見ると、何やら危ういカルトや宗教の始まりのように見えてしまうかもしれない。
だがインドは基本的に非常に宗教的な社会であり、伝統に根差した文化や生活習慣が、若い世代にも自然に染み込んでいる。
だから彼らが精神的な繋がりを周囲に求めた時、お互いに最も身近で違和感のない「共通言語」がバジャンだったとしても不思議ではないのだ。
新しい「文化」を好ましいと思う人もいれば批判する人も
とはいえ、批判がないわけではない。「信仰を商業化している」「パーティーの口実にしているだけだ」と眉をひそめる人々もいる。
実は最近になって、このバジャン・クラビングが国内外のネットやメディアで紹介されることが増えてきた。
それだけ大きなムーブメントになったのもあるが、商業的なイベントとして開催されることが多くなっており、宣伝としての意味合いも大きいようだ。
この画像を大きなサイズで見るそんな記事や映像を見たインドの人たちからは、さまざまな意見が寄せられていた。
- 現代のメンタルヘルスの問題と戦うには、若者にスピリチュアリティ(敢えて宗教とは言わないよ)を届ける必要がある。この取り組みをとても嬉しく思うよ
- これはインドにとって良い変化だ。ついに自分たちのルーツに戻り始めたんだ
- これはすばらしい。インド神話にはもともと踊りの形式や集団舞踊、祝祭がたくさんある。芸術や文化が宗教の中に組み込まれていて、恥や裁きを与えるものではないんだ
- 私もこういうイベントが大好き。最近はこういうグループがたくさんあって、何か引き寄せられるような重みがある。音のリズムと詠唱で行う瞑想みたいな感じ。もっと必要だと思う
- これは新しいことじゃない。ずっと昔からあった。単に若者のあいだでネットで流行っているだけだ
- ストレス解消のためのダンスと、信仰のためのダンスを混同しないでくれ。バジャンはストレス解消ではなく信仰だ。まずその意味を知れ。ストレス解消は他の方法でだってできるんだ
- インドでは宗教は良いビジネスモデルになっているね
- ヒッピーを覚えてる?80年代後半には、彼らは既にいろいろなバジャンをミックスしていた。別に新しいものじゃない
- 昔の村では、男女が夕方に集まって一緒に歌っていた。テレビや音楽プレーヤーがなかった頃のことだ。みんなこうやって日々の悩みやストレスを解放していた。今は現代的な形になっただけで、目的も体験も当時と同じに思える
- このパーティーでどれだけの「出会い」が発生しているんだろう
- 唯一の問題は、バジャンらしく品のある服を着るべきってことだね
この画像を大きなサイズで見る経済発展にともない、インドではライフスタイルや価値観が目まぐるしく変化し続けている。ともすれば世代間の断絶も生みかねない状況だ。
そんな中で、伝統に回帰する若者たちの姿は、保守的な世代にも好感を持って迎えられているようだ。
バジャン・クラビングが一時的な流行で終わるのか、それとも新たな文化として定着していくのかはまだわからない。
ただ、急速に変化する都市の中で、若者たちが自分なりの形で伝統に向き合い始めていることは確かなようだ。
References:Is 'bhajan clubbing' the coolest new way to party in India?

あわせて読みたい
もっと探索
歴史・文化
- 記事一覧を読込中です。
もっと探索
料理・健康・暮らし
- 記事一覧を読込中です。
この記事へのコメント 13件
インドネシアのバリ島に「ケチャ」と言う民族舞踊がありますが、それの現代的インド版って感じでしょうか
- 評価
ヨガも私ができるのはストレッチ程度なんだけどそれでも丁寧にやってるとなんか無意識のようなハイが訪れるよ
インドてこういうの好きなのかな- 評価
観客と一緒に楽しそうに歌ってるようにしかみえないな
- +4
日本人は精神的に静を重んじるけどほとんどの国は動なんだよな
- -1
インド版踊り念仏
- +8
シンガーズハイ
- 評価
現地の年輩者からすれば「軽薄に現代化した舞台でけしからん」なのかも知れないけど、
外から見てる分には、ヒンドゥー教って元々こういう賑やかに歌い踊って熱狂するイメージはある。30年くらい前の映画だけど、実際に起きたヒンドゥー教とイスラム教の対立暴動をテーマにした『ボンベイ』でも、それぞれの祭礼を対比的に描くシーンで、青色っぽい光調の静謐なモスク内で無言で額づき祈りを捧げるムスリム達に対し、ヒンドゥー教は派手に音楽が流れるオレンジ色っぽい照明?篝り火?の中で 舞台を観る群衆が皆で手を挙げて踊りの振付けに動かして沸いている場面なのが印象的だった。
- +1
ゴアトランスを生んだ国だしなあ
- +2
アルコールやドラッグに頼ってハイになるより、こうして「儀式」に参加する方が集中して行えていいと思う
一体感が強まるし、清々しい気持ちが残り、二日酔いもない
クラブで集まるっていうのも若者になじみのあるやり方でいいよね- 評価
一定のリズムで長時間歌う・踊るなどでトランス状態を目指すのは各宗教で昔から行われてきたことではあるよね
- +2
日本の昔のフォークコンサートとか。
- 評価
コメントを書く閉じる
世界の不思議が、
あなたの受信箱に。
いつでも簡単に配信停止できます。詳しくはカラパイア無料メールマガジン購読方法をご覧ください。
人気記事ランキング
第1位
第2位
第3位
第4位
第5位
第1位
第2位
第3位
第4位
第5位